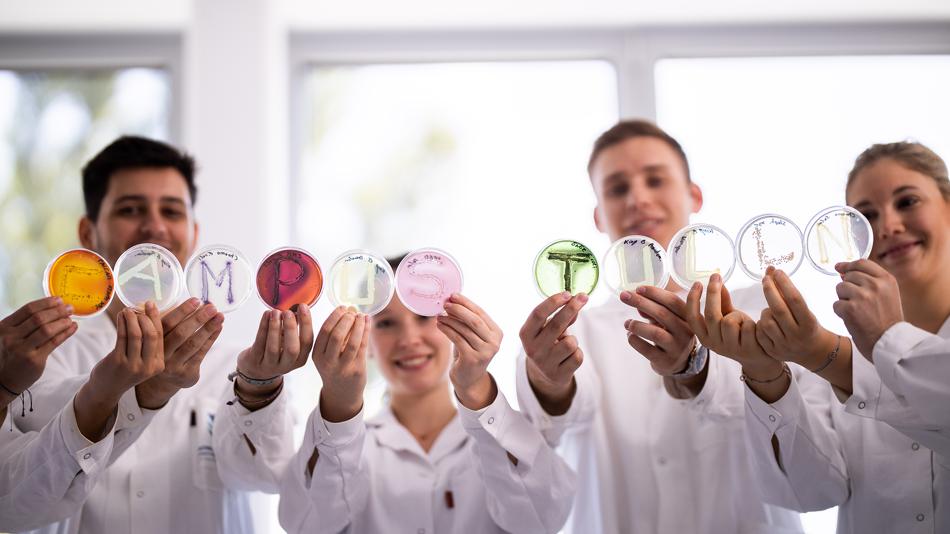
Bildungsinsel

Rahmenprogramm
Du willst Zukunft studieren? – Life Sciences and Digital Future
Ob moderne Medizin, nachhaltige Umwelttechnologien oder smarte digitale Anwendungen – die Zukunft braucht Menschen, die über Fachgrenzen hinausdenken, um neuartige Produkte oder Technologien zu entwickeln und zu optimieren. Bio Data Science verbindet Biologie, Informatik und Statistik, um aus großen Datenmengen verborgene Muster zu erkennen und so neue Einblicke in die Funktionsweise von Leben, Natur und komplexen biologischen Systemen zu gewinnen. Die Entwicklung von neuen Diagnosemöglichkeiten im medizinischen Bereich, die Optimierung von Nutzpflanzen für zukünftige klimatische Verhältnisse sowie nachhaltige Produktion und Recycling von Lebensmitteln, Textilien und Verpackungsmaterialien sind Forschungsfelder, die am Biotech Campus Tulln im Fokus stehen.
Studierenden werden modernste Labors, praxisnahe Forschung und Einblicke in aktuelle Projekte geboten. An dieser Station dreht sich alles um Zukunftsvisionen, Studienmöglichkeiten und spannende Forschungsfelder. Informiere dich über deine Perspektiven und über das Lehren, Lernen und Forschen am Campus.
Besucherinformation
Anfahrtsbeschreibung: Die Fachhochschule ist in einem Gebäudekomplex mit dem Haus der Digitalisierung untergebracht. Parkplätze sind am Campus ausreichend vorhanden.
Dieser Ausstellungsstandort ist barrierefrei zugänglich.
Öffnungszeiten
Kontakt
6 weitere Stationen an diesem Standort
-
 KinderprogrammWie sieht deine Zukunft aus? – kreative Jungforscher:inneninselThema: Gesellschaft NaturwissenschaftenJetzt und in der Zukunft brauchen wir kreative Köpfe! Deshalb laden wir alle von 0 – 99 dazu ein das Gemeinschaftsprojekt Zukunft mitzugestalten und ihre Zukunftsvision farbenfroh zu Papier zu bringen! Das Motto lautet: „Zeichne uns die Zukunft“ Gleichzeitig dürfen naturwissenschaftlich interessierte Besucher:innen auch praktisch in die Welt der Forschung reinschnuppern und biochemische Experimente ausprobieren.FH - Fachhochschule Wiener Neustadt17:00 - 23:00
KinderprogrammWie sieht deine Zukunft aus? – kreative Jungforscher:inneninselThema: Gesellschaft NaturwissenschaftenJetzt und in der Zukunft brauchen wir kreative Köpfe! Deshalb laden wir alle von 0 – 99 dazu ein das Gemeinschaftsprojekt Zukunft mitzugestalten und ihre Zukunftsvision farbenfroh zu Papier zu bringen! Das Motto lautet: „Zeichne uns die Zukunft“ Gleichzeitig dürfen naturwissenschaftlich interessierte Besucher:innen auch praktisch in die Welt der Forschung reinschnuppern und biochemische Experimente ausprobieren.FH - Fachhochschule Wiener Neustadt17:00 - 23:00 -
 MitmachstationReSTex Textilrecycling - kann man alte Textilien im Kreislauf halten?Thema: NaturwissenschaftenAlle reden über Fast-Fashion. Die bringt neue Shirts, Pants und Sweater im Überfluss. Die müssen in Zukunft recycelt werden. Aber woraus bestehen eigentlich unsere Textilien? "Begreife" den Unterschied zwischen den Stoffen und schau dir die Strukturen unter dem Mikroskop an. Und wie funktionieren Textilrecycling? Reduce - Reuse - Recycle: kann ich da auch etwas beitragen?FH - Fachhochschule Wiener Neustadt17:00 - 23:00
MitmachstationReSTex Textilrecycling - kann man alte Textilien im Kreislauf halten?Thema: NaturwissenschaftenAlle reden über Fast-Fashion. Die bringt neue Shirts, Pants und Sweater im Überfluss. Die müssen in Zukunft recycelt werden. Aber woraus bestehen eigentlich unsere Textilien? "Begreife" den Unterschied zwischen den Stoffen und schau dir die Strukturen unter dem Mikroskop an. Und wie funktionieren Textilrecycling? Reduce - Reuse - Recycle: kann ich da auch etwas beitragen?FH - Fachhochschule Wiener Neustadt17:00 - 23:00 -
 Experiment / VorführungLaserblick in die Zelle – Science oder Fiction?Thema: Digitalisierung NaturwissenschaftenZellen reagieren auf äußere Einflüsse, doch ihre Veränderungen sind für uns nicht direkt sichtbar. Die Kombination aus Mikroskopie, winzigen Goldpartikeln und Laserstrahlen gemeinsam mit modernster digitaler Datenverarbeitung ermöglicht es, vielfältige Informationen von Zellen mit der Raman-Spektroskopie zu erhalten. Zum Beispiel, wie sich eine Krebszelle verändert, wenn sie mit Medikamenten behandelt wird.FH Wiener Neustadt17:00 - 23:00
Experiment / VorführungLaserblick in die Zelle – Science oder Fiction?Thema: Digitalisierung NaturwissenschaftenZellen reagieren auf äußere Einflüsse, doch ihre Veränderungen sind für uns nicht direkt sichtbar. Die Kombination aus Mikroskopie, winzigen Goldpartikeln und Laserstrahlen gemeinsam mit modernster digitaler Datenverarbeitung ermöglicht es, vielfältige Informationen von Zellen mit der Raman-Spektroskopie zu erhalten. Zum Beispiel, wie sich eine Krebszelle verändert, wenn sie mit Medikamenten behandelt wird.FH Wiener Neustadt17:00 - 23:00 -
 Experiment / VorführungVom Reagenzglas in die Zelle – Wie können winzige Transporthüllen Medikamente sicher in Zellen transportieren?Thema: NaturwissenschaftenViele Medikamente, aber auch RNA sind empfindlich und können Zellen nicht einfach so erreichen. Besucher erfahren hier, wie Lipid Nanopartikel als Transporthüllen diese Stoffe schützen, transportieren und gezielt freisetzen. Durch anschauliche Modelle und Bilder wird sichtbar, wie Forschende RNA verpacken und kontrolliert in Zellen einschleusen.FH - Fachhochschule Wiener Neustadt17:00 - 23:00
Experiment / VorführungVom Reagenzglas in die Zelle – Wie können winzige Transporthüllen Medikamente sicher in Zellen transportieren?Thema: NaturwissenschaftenViele Medikamente, aber auch RNA sind empfindlich und können Zellen nicht einfach so erreichen. Besucher erfahren hier, wie Lipid Nanopartikel als Transporthüllen diese Stoffe schützen, transportieren und gezielt freisetzen. Durch anschauliche Modelle und Bilder wird sichtbar, wie Forschende RNA verpacken und kontrolliert in Zellen einschleusen.FH - Fachhochschule Wiener Neustadt17:00 - 23:00 -
MitmachstationEnzyme im Bier & Nahrungsmittelintoleranzen (Enzyme und Histamin bzw. Gluten in Lebensmitteln am Beispiel Bier)Thema: GesundheitBeschwerden nach Biergenuss? Könnte das am Histamin- oder Glutengehalt des Bieres liegen? Wie kommen Histamin und Gluten ins Bier und welche Rolle spielen dabei Enzyme?SCIOTEC Diagnostic Technologies GmbH17:00 - 23:00
-
MitmachstationWas verrät Speichel über Belastung und Erholung? Massenspektrometrie macht Körpersignale sichtbarThema: GesundheitWas verrät Speichel über Belastung und Erholung? In einem kurzen Spiel suchen Besucher:innen in einem „Molekül-Fingerabdruck“ (Massenspektrum) typische Peak-Muster und ordnen sie einem Szenario zu. So wird verständlich, wie Forschung aus Messsignalen Hinweise auf Stress, Schlaf und Regeneration ableitet.BIOLYZ FlexCo17:00 - 23:00